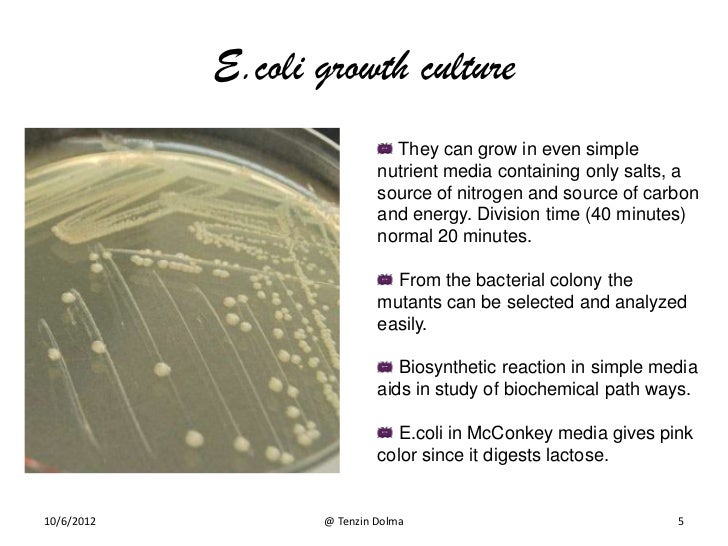
E coli

If you are looking for Bakteri Escherichia Coli (E.Coli) dan Penyakit yang Ditimbulkan you've came to the right web. We have 9 Pictures about Bakteri Escherichia Coli (E.Coli) dan Penyakit yang Ditimbulkan like E coli Bacteria - Stock Image - C007/9336 - Science Photo Library, ESBL E.Coli UTI infection in urine: Treatment and Prevention and also Pin on Microbiology. Here you go:
Bakteri Escherichia Coli (E.Coli) Dan Penyakit Yang Ditimbulkan
 www.sehatq.com
www.sehatq.com coli escherichia bakteri ditimbulkannya gangguan seputar picu bisa
Sweat Rash - Pictures, Treatment, Symptoms, Causes | Med Mum
sweat rash sponsored link treatment
CLED Agar: Composition, Uses And Typical Colony Characteristics
cled agar colonies lactose culture colony non bacterial ph yellow fermenting characteristics coli proteus escherichia salmonella fermenters deficient electrolyte composition
E Coli
www.slideshare.net
www.slideshare.net coli
E Coli Bacteria - Stock Image - C007/9336 - Science Photo Library
 www.sciencephoto.com
www.sciencephoto.com coli bacteria
ESBL E.Coli UTI Infection In Urine: Treatment And Prevention
 healthncare.info
healthncare.info uti esbl ecoli
How We Report White Blood Cells Count In Urinalysis | Medical Laboratories
blood count urinalysis cells report medical
Pin On Microbiology
 www.pinterest.com
www.pinterest.com leucine crystal urine crystals calcium microbiology oxalate sediment microscope
Infezioni E Malattie Infettive: Batteri Benefici
 infezioni.blogspot.com
infezioni.blogspot.com uti coli urinary tract infections batteri benefici sarcina bladder bacteria kako escherichia ispucale negovati causes urethra kakopedija exista utis begin
Cled agar: composition, uses and typical colony characteristics. Blood count urinalysis cells report medical. E coli